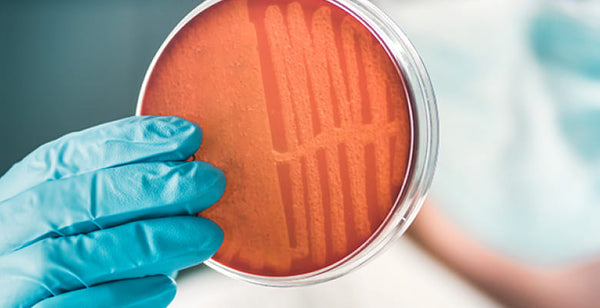

Exclusive Offer: 30% Off 1st Order* with code SAVE30
Exclusive Offer: 30% Off 1st Order* with code SAVE30
Exclusive Offer: 30% Off 1st Order* with code SAVE30
Exclusive Offer: 30% Off 1st Order* with code SAVE30
Hey Gillian 👋

Persephone Biosciences is a team of scientists, researchers, and physicians dedicated to restoring and reinvigorating the human gut microbiome.

Our Inspiration
Persephone is the goddess
of growth, love, and fertility.
She’s a symbol of the re-emergence of life each spring. She is also associated with the pomegranate, an acknowledgment of the fruit’s healthful properties, now known to have prebiotic effects.
Ultimately, we chose the name Persephone because we are here to return life to the gut and bring good health into bloom for everyone.
Our Mission
Our mission is to establish the standard
of care for the human gut microbiome.
of care for the human gut microbiome.
We are accomplishing this through our pioneering research, the development of effective and clinically proven products, and by advancing the industry with our platform technology.
Our Research
The largest and most comprehensive study ever conducted in the U.S. to map the infant gut microbiome.


Our Products
The first complete synbiotic for infants and toddlers. Our My Baby Biome study** identified and isolated the missing bacteria in today’s babies and paired them with the precise prebiotics they need to thrive. This formula restores essential microbes to support lifelong gut and immune health.
Rooted in collaboration with
leaders in science and health
leaders in science and health
Our partners

Our investors




Press

Business Wire
Persephone Biosciences Announces New Collaboration With Kroger Health to Launch AMBROSIA Food as Medicine Study